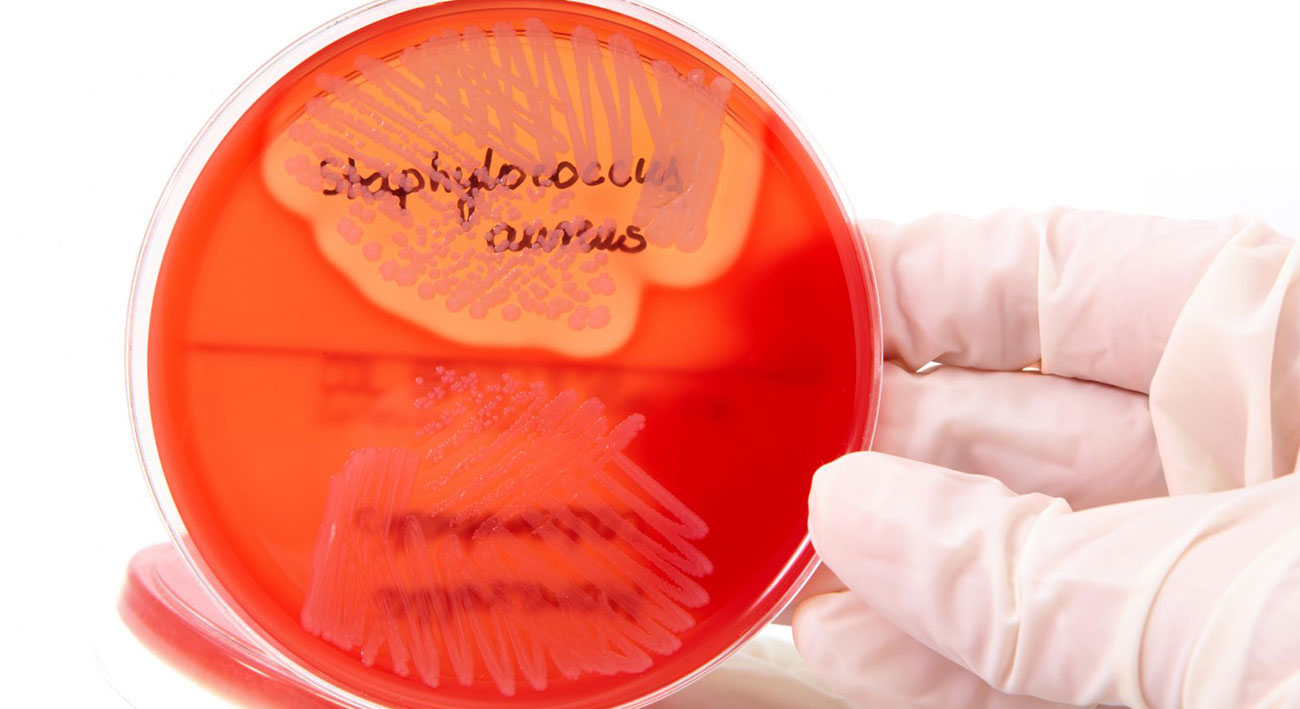

The Lancet: устойчивость к антибиотикам губит больше людей, чем ВИЧ и малярия
Устойчивость бактерий к антибиотикам — одна из ведущих причин смертности в мире. Об этом сообщает команда медиков в редакционной колонке в престижном научном журнале The Lancet. Авторы статьи бьют тревогу: из-за антибиотикорезистентности умирает больше людей, чем от малярии и ВИЧ. Так, в 2019 году смерть 4,95 млн человек была связана с инфекциями, резистентными к воздействию лекарств.
Больше всего смертей, связанных с устойчивостью к антибиотикам, вызваны кишечной палочкой (Escherichia coli) и метициллинрезистентным золотистым стафилококком (Staphylococcus aureus). В 2017 году ВОЗ назвала метициллинрезистентный золотистый стафилококк серьёзной угрозой для человечества.
По словам авторов колонки, устойчивость к антибиотикам — глобальная проблема, которую срочно надо решать. И в первую очередь она должна быть осознана как реальная глобальная угроза, а не как некий абстрактный риск для здоровья, который можно игнорировать: политическим лидерам следует уделять борьбе с антибиотикорезистентностью значимое место в программах, необходимы широкое общественное освещение проблемы и эффективный контроль над использованием антибиотических препаратов (к сожалению, многие врачи прописывают пациентам антибиотики без необходимости). Следует улучшить доступ населения (прежде всего стран Африки к югу от Сахары и Южной Азии) к наиболее эффективным из уже существующих антибиотиков, к чистой воде и санитарии. Также авторы напоминают о жизненной необходимости увеличения усилий в направлении разработки новых антибиотических препаратов, к которым у микроорганизмов пока не выработалась резистентность, и вакцин. Для этого, разумеется, нужны серьёзные инвестиции.
Авторы статьи видят, как минимум, одну возможность привлечения инвестиций в эту жизненно важную для человечества отрасль исследований. В этом году должен собраться на седьмую встречу для пополнения средств Глобальный фонд борьбы со СПИДом, туберкулёзом и малярией (The Global Fund to Fight AIDS, Tuberculosis and Malaria). Этой международной партнёрской организации, считают авторы колонки, следует использовать это собрание, чтобы пересмотреть свою миссию, расширив её в т.ч. на борьбу с антибиотикорезистентностью, а донаторам Фонда — щедро жертвовать на решение этой проблемы.
Источник: XX2 ВЕК
